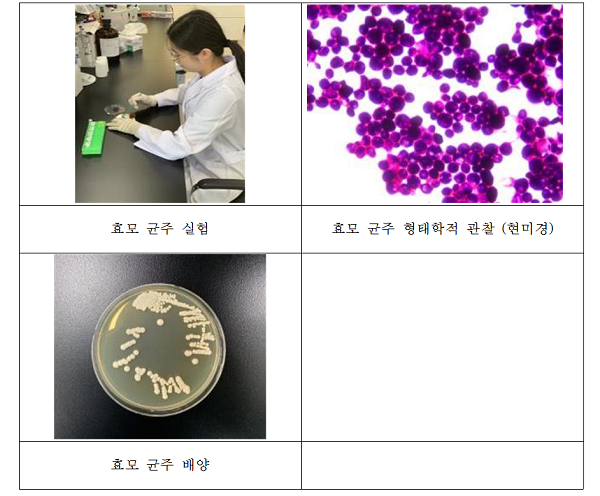

토종 효모를 이용한 최고의 와인 탄생
충청북도농업기술원은 와인 생산용 효모 균주에 관한 특허를 지난 26일 출원했다고 밝혔다.
와인연구소는 지난 3년간 국내에서 재배되는 품종 캠벨얼리, 머루 등 17종을 수집해 와인으로 발효시킨 후, 약 3,956종의 효모 균주를 수집했다. 토종 효모 균주 중에서 와인 양조에 적합한 균주를 선별해 최종적으로 와인 양조에 적합한 균주를 선정한 것이다.
이번 특허 균주는 높은 알코올 농도와 당 농도에서도 생육이 가능하고, 기존의 외국산 시판 효모 균주보다 생리활성이 뛰어난 것으로 나타났다. 특히 국산 와인의 부족한 탄닌 함량이 높았으며, 안토시아닌 함량은 2배가량 높은 수치를 나타내었다.
특허 균주로 제조한 와인은 우리나라 소비자들이 선호하는 향기성분인 꽃향기와 과일향을 나타내는 에스테르 화합물이 기존의 외국산 효모보다 2배 이상 많은 것으로 나타났으며, 그 외에 다양한 향기 성분들이 다량으로 존재했다.
이번 국산 포도 품종에 적합한 효모의 발굴을 통해 외국 와인과 비교해도 손색이 없을 고품질 국산 와인이 제조 가능하게 되었고, 이를 통해 국내 소비자들은 뛰어난 품질의 한국와인을 즐길 수 있게 됐다..
와인연구소 노재관 소장은“이번 특허를 통해 생산되는 와인은 국내 와인 시장에서 한국 와인의 위상을 높이며 그 가치를 인정받을 수 있을 것이고, 앞으로 와인연구소는 한국 와인의 고급화에 한걸음 더 나아갈 수 있도록 노력하겠다.”라고 말했다.
KPI뉴스 / UPI뉴스 기자
[ⓒ KPI뉴스. 무단전재-재배포 금지]


